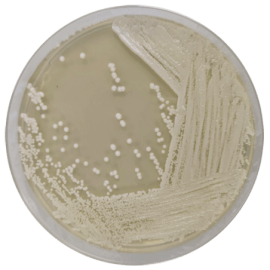
main product photo

Close
MALT EXTRACT AGAR 500 grams/bottle
SKU
CDL/1038
Brand
CONDALAB
Pre-order (Deliver in 8 to 12 weeks)
Malt Extract Agar is used for the isolation, cultivation and enumeration of yeasts and molds from foods.
It is particularly suitable for yeasts and molds as it contains a high concentration of maltose and other saccharides as energy sources. Dextrin and glycerin are the carbon sources, and peptone is a nitrogen source. Bacteriological agar is the solidifying agent. The acidic pH of the Malt Extract Agar is optimum for the growth of yeasts and molds whilst restricting other bacterial growth.
Malt Extract Agar has been used for years to cultivate fungi and yeast cultures in the sugar industry, in the manufacturing of syrups, soft drinks, and other drinks.
Malt Extract Agar is used for the isolation, cultivation and enumeration of yeasts and molds from foods.
It is particularly suitable for yeasts and molds as it contains a high concentration of maltose and other saccharides as energy sources. Dextrin and glycerin are the carbon sources, and peptone is a nitrogen source. Bacteriological agar is the solidifying agent. The acidic pH of the Malt Extract Agar is optimum for the growth of yeasts and molds whilst restricting other bacterial growth.
Malt Extract Agar has been used for years to cultivate fungi and yeast cultures in the sugar industry, in the manufacturing of syrups, soft drinks, and other drinks.
| Brand | CONDALAB |
|---|
Write Your Own Review

Validate your login